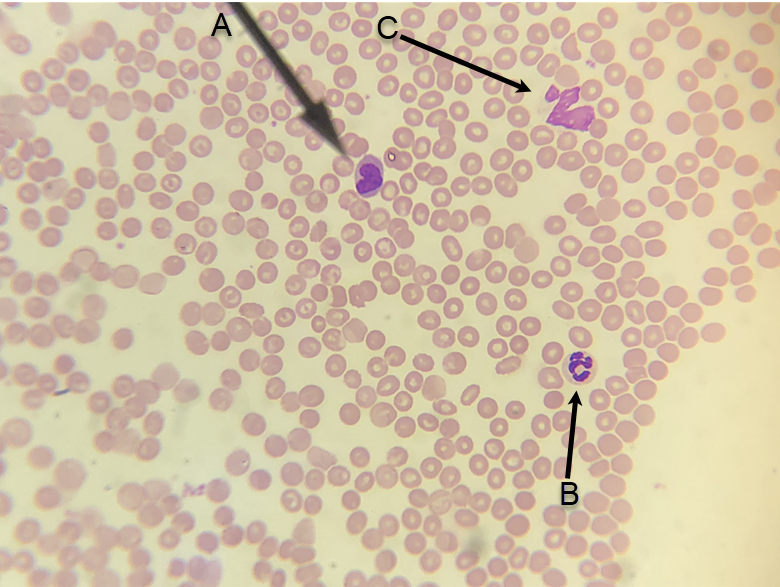
<p>In the image above, identify formed elements A and B.&nbsp; (For fun:&nbsp; formed element C ruptured, but do you have a guess as to what it was?)</p>
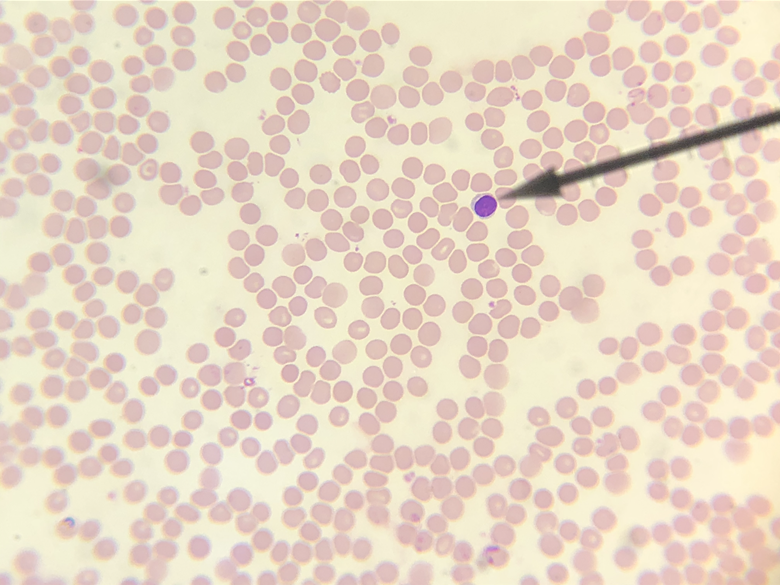
<p>I<span>n the image above, identify the formed element at the tip of the pointer.</span></p>
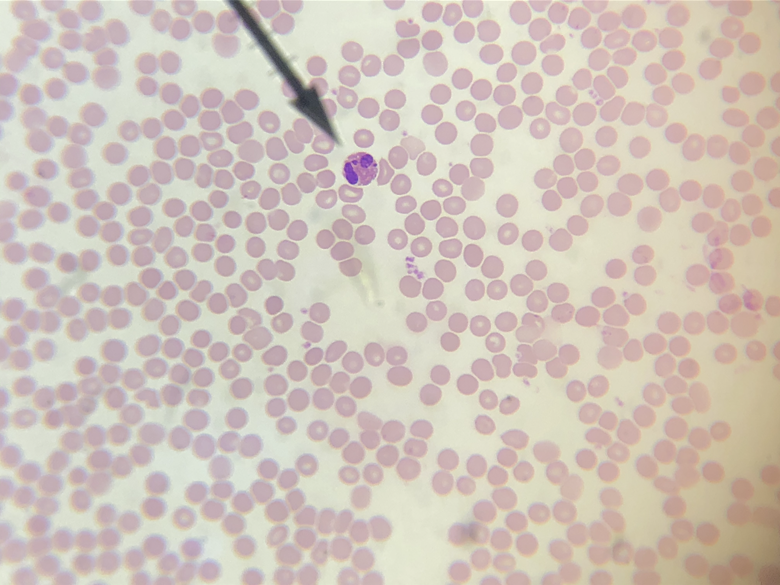
<p>I<span>n the image above, identify the formed element at the tip of the pointer.</span></p>
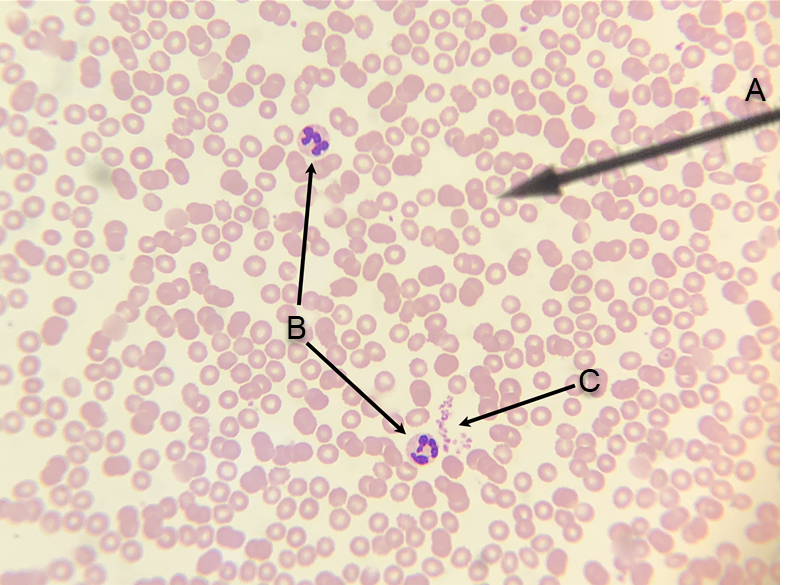
<p>I<span>n the image above, identify formed elements A, B, and C.</span></p>

1/41
Looks like no tags are added yet.
Name | Mastery | Learn | Test | Matching | Spaced | Call with Kai |
|---|
No analytics yet
Send a link to your students to track their progress

In the image above, identify the formed element at the tip of the pointer.
red blood cell
In the image above, identify formed elements A and B. (For fun: formed element C ruptured, but do you have a guess as to what it was?)
A. monocyte
B. neutrophil
C. monocyte or neutrophil?
In the image above, identify the formed element at the tip of the pointer.
lymphocyte

This one (above) is a little weird, but you should still be able to identify the formed element at the tip of the pointer.
monocyte

In the image above, identify the formed element at the tip of the pointer.
eosinophil

In the image above, identify formed elements A and B.
A. monocyte
B. neutrophil
In the image above, identify the formed element at the tip of the pointer.
eosinophil

In the image above, identify the formed element at the tip of the pointer.
basophil

In the image above, identify formed elements A, B, and C.
A. lymphocyte
B. neutrophil
C. platelet
In the image above, identify formed elements A, B, and C.
A. red blood cell
B. neutrophils
C. platelets

In the image above, identify the formed elements at the tip of the pointer
platelets

In the image above, identify specific blood vessel types A and B.
A. arteries
B. vein

In the image above, identify specific blood vessel types A and B.
A. artery
B. veins

In the image above, identify specific blood vessel types A and B, and specific wall layers C, D, and E.
A. arteries
B. vein
C. tunica externa
D. tunica media
E. tunica intima

In the image above, identify specific blood vessel wall layers A, B, and C.
A. tunica intima
B. tunica media
C. tunica externa

In the image above, identify specific blood vessel wall layer A, and structure B.
A. tunica externa
B. venous valve

In the images above and below, identify shallow depression A; and blood vessels B and C.
A. anterior interventricular sulcus
B. coronary a.
C. coronary v.

In the images above and below, identify shallow depression A; and blood vessels B and C.
A. anterior interventricular sulcus
B. coronary a.
C. coronary v.

in the images above and below, identify shallow depression A; and blood vessels B, C, D, E, F, G, H, and J. (There is no letter I.)
A. posterior interventricular sulcus
B. coronary v.
C. coronary sinus
D. coronary a.
E. pulmonary v.
F. inferior vena cava
G. pulmonary a.
H. superior vena cava
J. aorta

in the images above and below, identify shallow depression A; and blood vessels B, C, D, E, F, G, H, and J. (There is no letter I.)
A. posterior interventricular sulcus
B. coronary v.
C. coronary sinus
D. coronary a.
E. pulmonary v.
F. inferior vena cava
G. pulmonary a.
H. superior vena cava
J. aorta

In the images above and below (which are superior views of the heart), identify blood vessels A, B, C (above image only), D, and E (below image only).
A. superior vena cava
B. aorta
C. pulmonary trunk
D. pulmonary a.
E. pulmonary v.

In the images above and below (which are superior views of the heart), identify blood vessels A, B, C (above image only), D, and E (below image only).
A. superior vena cava
B. aorta
C. pulmonary trunk
D. pulmonary a.
E. pulmonary v.

In the images above and below, identify chambers A, B, C, and D; blood vessels E, F, and G; structures H, J, K (above image only), L, M, and N; and layers of the heart wall O, P, and Q (below image only). (There is no letter I.)
A. right atrium
B. left atrium
C. right ventricle
D. left ventricle
E. superior vena cava
F. aorta
G. pulmonary trunk
H. right AV valve
J. left AV valve
K. pulmonary valve
L. chordae tendineae
M. papillary muscle
N. interventricular septum
O. myocardium
P. endocardium
Q. epicardium

In the images above and below, identify chambers A, B, C, and D; blood vessels E, F, and G; structures H, J, K (above image only), L, M, and N; and layers of the heart wall O, P, and Q (below image only). (There is no letter I.)
A. right atrium
B. left atrium
C. right ventricle
D. left ventricle
E. superior vena cava
F. aorta
G. pulmonary trunk
H. right AV valve
J. left AV valve
K. pulmonary valve
L. chordae tendineae
M. papillary muscle
N. interventricular septum
O. myocardium
P. endocardium
Q. epicardium

In the images above and below, identify blood vessels A, B, C, and D; structures E, F, G, H, and J; and chambers K and L. (There is no letter I.)
A. superior vena cava
B. inferior vena cava
C. aorta
D. pulmonary trunk
E. fossa ovalis
F. right AV valve
G. pulmonary valve
H. chordae tendineae
J. papillary muscle
K. right atrium
L. right ventricle

In the images above and below, identify blood vessels A, B, C, and D; structures E, F, G, H, and J; and chambers K and L. (There is no letter I.)
A. superior vena cava
B. inferior vena cava
C. aorta
D. pulmonary trunk
E. fossa ovalis
F. right AV valve
G. pulmonary valve
H. chordae tendineae
J. papillary muscle
K. right atrium
L. right ventricle

In the images above and below, identify blood vessels A, B, and C; structures D, E, F, and G; and chambers H and J. (There is no letter I.)
A. aorta
B. pulmonary trunk
C. pulmonary v.
D. aortic valve
E. left AV valve
F. chordae tendineae
G. papillary muscle
H. left atrium
J. left ventricle

In the images above and below, identify blood vessels A, B, and C; structures D, E, F, and G; and chambers H and J. (There is no letter I.)
A. aorta
B. pulmonary trunk
C. pulmonary v.
D. aortic valve
E. left AV valve
F. chordae tendineae
G. papillary muscle
H. left atrium
J. left ventricle

In the images above and below, identify muscular structures A, B, and C; and layers of the heart wall D, E, and F (below image only). (The image below is slightly out of focus, but you should still be able to identify everything, especially if you use the image above as a reference.)
A. pectinate muscles
B. trabeculae carneae
C. papillary muscles
D. myocardium
E. endocardium
F. epicardium

In the images above and below, identify muscular structures A, B, and C; and layers of the heart wall D, E, and F (below image only). (The image below is slightly out of focus, but you should still be able to identify everything, especially if you use the image above as a reference.)
A. pectinate muscles
B. trabeculae carneae
C. papillary muscles
D. myocardium
E. endocardium
F. epicardium

In the image above, identify blood vessels A, B, C, and D.
A. common carotid a.
B. internal jugular v.
C. subclavian v.
D. brachiocephalic v.

In the image above, identify blood vessels A, B, C, D, E, F, G, H (it's red), and J. (There is no letter I.)
A. subclavian v.
B. pulmonary a.
C. pulmonary v.
D. brachiocephalic v.
E. superior vena cava
F. common carotid a.
G. internal jugular v.
H. subclavian a.
J. aorta

In the image above, identify blood vessels A, B, C, D, E, F, G, H, J, and K. (There is no letter I.)
A. inferior vena cava
B. adrenal (suprarenal) a.
C. splenic a.
D. splenic V.
E. common iliac a.
F. common iliac v.
G. external iliac a.
H. external iliac v.
J. femoral a.
K. femoral v.

In the image above, identify blood vessels A, B, C, D, E, G, and H.
A. common iliac a.
B. common iliac v.
C. internal iliac a.
D. external iliac a.
E. external iliac v.
G. femoral a.
H. femoral v.

In the image above (which is the inside of the anterior wall of the ventral cavity), identify blood vessel A (it's red).
A. internal thoracic a.

In the image above, identify blood vessels A, B, C, D, E, F, G, H, J, and K. (There is no letter I.)
A. superficial temporal a.
B. facial a.
C. superior thyroid a.
D. vertebral a.
E. subclavian v.
F. subclavian a.
G. superior vena cava
H. aorta
J. pulmonary trunk
K. Internal jugular vein

In the image above, identify blood vessels A, B, C, D, E, F, G, H, J, K, L, M, N, O, P, Q, R, and S. (There is no letter I.)
A. common hepatic a.
B. splenic a.
C. splenic v.
D. renal v.
E. renal a.,
F. inferior vena cava
G. aorta
H. inferior mesenteric a.
J. common iliac a.
K. common iliac v.
L. external iliac a.
M. external iliac v.
N. internal iliac v.
O. internal iliac a.
P. femoral a.
Q. Celiac trunk
R. Superior mesenteric v.
S. Left gastric a.

In the image above, identify blood vessels A, B, C, D, E, F, and G.
A. axillary a.
B. axillary v.
C. cephalic v.
D. brachial a.
E. thoracodorsal a.
F. ulnar a.
G. radial a.

In the image above, identify blood vessels A, B, C, D, E, F, and G.
A. femoral a.
B. great saphenous v.
C. popliteal a.
D. anterior tibial a.
E. posterior tibial a.
F. small (lesser) saphenous v.
G. dorsalis pedis a. (Dorsal pedis)

Name A-D
A. Superficial temporal artery
B. Facial artery and vein
C. External carotid artery
D. Superior thyroid artery

Identify A-N
A. Superior thyroid artery
B. Common carotid artery
C. Vertebral artery
D. Thyrocervical trunk
E. Subclavian artery and vein
F. Superior vena cava
G. Aorta
H. Axillary artery and vein
I. Cephalic vein
J. Thoracodorsal Artery
K. Left subclavian artery
L. Brachial artery and vein
M. Basilic vein
N. Pulmonary trunk

Name A-M
A. Common carotid artery
B. Thyrocervical trunk
C. Vertebral artery
D. Left subclavian artery
E. Subclavian artery and vein
F. Internal jugular vein
G. Cephalic vein
H. Aorta
I. Superior vena cava
J. Axillary artery and vein
K. Brachial artery and vein
L. Thoracodorsal Artery
M. Pulmonary trunk